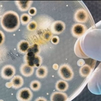
La clave de la longevidad podría estar en el intestino

"Hay bacterias que tienen que estar en el intestino, pero que no nos gustaría tener dispersándose por todas las partes", según la experta en microbiota y doctora en Ciencias Biomédicas, Sari Arponen, que recomienda bajar la tapa del váter al tirar de la cadena y no ir al baño con el teléfono móvil.
Arponen, docente y divulgadora, acaba de publicar 'El mundo secreto de la microbiota' (Planeta), un libro con ilustraciones de Lirios Bou "para aprender a cuidar los bichitos de nuestro cuerpo".
Tras el éxito de '¡Es la microbiota, idiota! o 'El sistema inmunitario por fin sale del armario', la especialista en Medicina Interna explica en una entrevista con EFE que ha dedicado este manual a los más pequeños porque "son como esponjas y si adquieren hábitos saludables les pueden durar toda la vida".
La doctora insiste en la importancia de la microbiota, "ese conjunto de microorganismos que tenemos en el cuerpo, en la boca, en el intestino o en la piel, con muchas funciones para tener una salud óptima cuando está en un estado de equilibrio".
En este sentido, asegura que "la microbiota nos devolverá todo lo que le damos", por lo que anima a "tomar acción" porque "nuestra salud está en gran medida en nuestras manos".
Microbiota desequilibrada
"Cualquier problema de salud puede esconder un desequilibrio de la microbiota (una disbiosis), como las alteraciones en las deposiciones -tanto estreñimiento como diarrea-, o muy mal olor, así como tendencia a tener la tripa muy hinchada, o que siempre siente mal la comida", relata Arponen.
Son los síntomas más frecuentes del desequilibrio, pero también la dermatitis, los dolores de cabeza sin causa aparente o enfermedades más graves como el parkinson y el alzheimer.
Analizar la microbiota fecal
Arponen lamenta que los análisis de microbiota no sean aún una realidad en la práctica clínica. "Los de microbiota fecal son todavía bastante caros y tampoco existe suficiente estandarización como para conocer su correlación con las enfermedades".
Pese a ello, la doctora insiste en divulgar el cuidado de la microbiota, para tenerla más saludable y equilibrada, y tener una población más sana.
Alimentos de verdad
Si son alimentos de verdad, a la microbiota le puede gustar prácticamente todo, asegura la experta, y enumera la verdura, la fruta, el aceite de oliva, las legumbres cocinadas de una manera adecuada, los productos del mar, los frutos secos o los fermentados, como los yogures, el queso.
Sin embargo, es muy reacia a los productos ultraprocesados, como la bollería industrial, alimentos con muchísima azúcar, con harinas refinadas, con grasas trans industriales o con aditivos, que "no aportan nada beneficioso desde ningún punto de vista".
El sedentarismo, la falta de sueño y el estrés ponen al organismo en estado de alerta. Además de la alimentación, el sedentarismo es "nefasto" para la microbiota porque es "antinatural". "El ser humano sano y normal se mueve. Lo que es raro es estar quieto. Cuando no utiliza sus músculos o sus huesos sufre el cerebro y el sistema inmunitario", advierte Arponen.
También se resiente la microbiota por la falta de sueño. "Somos el único animal que voluntariamente renuncia al descanso cuando estamos casados o que dejamos de dormir por hacer actividades como estar en el sofá tirados viendo la tele hasta altas horas de la madrugada".
A esos dos factores la doctora une el estrés. Pero no el puntual ante una situación de riesgo, sino "al montón de cosas que nos estresan de manera crónica y continua: las hipotecas, el ver noticias sobre la política, etc. Eso nos genera una reacción de alarma, que no podemos solucionar, que afecta al cerebro y al sistema inmunitario, y que capta el sistema endocrino".
El eje intestino-cerebro
"Lo que pasa en el intestino no se queda en el intestino. A través del nervio vago y por las sustancias que se generan y llegan al cerebro, como el butirato, van a influir en su funcionamiento".
Además, la microbiota desequilibrada puede generar una situación de inflamación crónica de bajo grado en el cerebro (neuroinflamación de las células de soporte de las neuronas) que, a su vez, originarían trastornos del estado de ánimo, o patologías mayores, como enfermedades neurodegenerativas, problemas de memoria o cognitivos.
Por ello, recuerda que se empieza a hablar de la "psiquiatría nutricional" y de los "psicobióticos" para "utilizar cierta cepa de probióticos que ayude a funcionar mejor el cerebro".
El móvil, uso limitado y en su lugar
No solo desaconseja llevar el móvil al baño "porque por mucho que te laves las manos, si hay bacterias en el móvil, las tendrás de nuevo en la manos cuando lo cojas", sino que advierte de lo nefasto que es su uso durante las comidas.
Según Arponen, si no ponemos el foco en el acto de comer nos podemos estresar con los estímulos que mantienen al cerebro pendiente de otras cosas, además de que no nos damos cuenta de lo que estamos comiendo ni de cuanto, no masticamos las veces suficientes y no predisponemos la digestión.